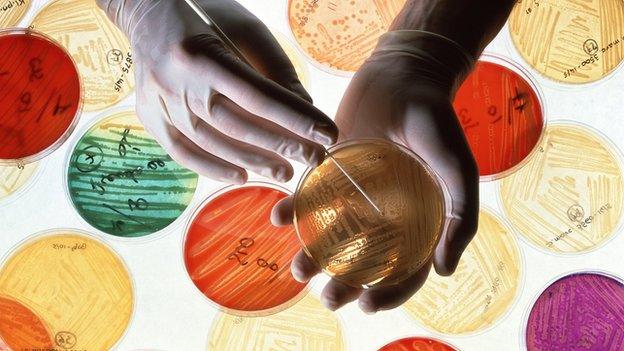
antibiotic research

Nearly one in seven antibiotic treatments given out by GPs for common infections over the last two decades in the UK have failed, researchers say.
The Cardiff University study assessed nearly 11m prescriptions handed out between 1991 and 2012, to establish the level of antibiotic resistance.
Overall researchers found the drugs failed in just under 15% of cases.
But they said the rise seen over the 22-year period - from 13.9% to 15.4% - was not as great as they had expected.
Report author Prof Craig Currie said while this was not quite the "cliff" that many people had feared, it was still concerning.
"Given the lack of new antibiotics being developed, the growing ineffectiveness of antibiotics is very worrying indeed.
"There is a mistaken perception that antibiotic resistance is only a danger for hospital patients.
"We need to ensure that patients receive the appropriate medication of their condition and minimise any unnecessary or inappropriate treatment which could be fuelling resistance, prolonging illness and in some cases killing people."
'Huge concern'
During the study, which was funded by drugs firm Abbott Healthcare Products and is published in the British Medical Journal, researchers looked at patients given antibiotics for infections ranging from skin and ear complaints, to those affecting the chest, throat and sinuses.
To establish which prescriptions were failing, the team looked at which patients needed an alternative treatment within 30 days of the prescription being issued, or if the patient was admitted to hospital, or died with an infection-related illness.
This is not proof of resistance developing, but it is considered a reasonable way of estimating it.
The period which saw the biggest increase in antibiotic failure - 2000 to 2012 - was also the period when more patients began to be treated with the drugs.
Between those years the proportion of patients with infections who were given antibiotics, rose from 60% to 65%.
Edinburgh University infectious disease expert Prof Mark Woolhouse said the research was welcome because while antibiotic resistance was a "huge concern", there was a "paucity of hard data" available.
"We are increasingly reliant on a dwindling arsenal of drugs. That supports calls to develop new drugs but also, and probably even more importantly in the long term, to reduce usage and develop alternative therapies."
Prof Mark Fielder, of Kingston University, agreed, adding: "There is a continued need for education across the spectrum with both patients and medical professionals being aware of the importance of this issue."
- Published11 March 2013

- Published19 November 2015

- Published19 November 2015

- Published11 March 2013

- Published27 February 2013

- Published30 November 2012

- Published15 February 2013

- Published24 January 2013

- Published19 December 2012
